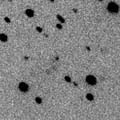

Click! Click! |
Nov. 9, 2005
Toni Scarmato
|
Click! Click! |
Nov. 4, 2005
Toni Scarmato
|
 Click! Click! |
Oct. 27, 2005
Toni Scarmato
|
 Click! Click! |
Oct. 27, 2005
Jean-Benoit de Vanssay
|
 Click! Click! |
Oct. 25, 2005
Toni Scarmato
|
 Click! Click! |
Oct. 9, 2005
Rolando Ligustri
|
 Click! Click! |
Oct. 8, 2005
Veijo Kallio
|
 Click! Click! |
Oct. 7, 2005
Albert Sanchez Caso
|
 Click! Click! |
Sept. 30, 2005
Albert Sanchez Caso
|
 Click! Click! |
Sept. 23, 2005
Jean-Benoit de Vanssay
|
 Click! Click! |
Sept. 13, 2005
Rolando Ligustri
|
 Click! Click! |
Sept. 9, 2005
Albert Sanchez Caso
|
 Click! Click! |
Sept. 5, 2005
Pertti Paakkonen
|
 Click! Click! |
Sept. 3, 2005
Roberto Haver
|
 Click! Click! |
Aug. 31, 2005
Michael Jager & Gerald Rhemann
|
 Click! Click! |
Aug. 9, 2005
Takbou Stephane
|
 Click! Click! |
Aug. 8, 2005
Rolando Ligustri
|
 Click! Click! |
Aug. 7, 2005
Albert Sanchez Caso
|
 Click! Click! |
Aug. 5, 2005
Rolando Ligustri
|
 Click! Click! |
Aug. 3, 2005
Takbou Stephane
|
 Click! Click! |
Aug. 1, 2005
Michael Mattiazzo
|
 Click! Click! |
Aug. 1, 2005
Michael Jager
|
 Click! Click! |
July 18, 2005
Francois Kugel
|
 Click! Click! |
July 18, 2005
Michael Jager & Gerald Rhemann
|
 Click! Click! |
July 15, 2005
Takbou Stephane
|
 Click! Click! |
July 15, 2005
Michael Jager & Gerald Rhemann
|
 Click! Click! |
July 9, 2005
Rolando Ligustri
|
 Click! Click! |
July 5, 2005
E. Guido and G. Sostero
|
 Click! Click! |
May 12, 2005
Michael Mattiazzo
|
 Click! Click! |
Jan. 20, 2005
John Drummond
|
 Click! Click! |
Jan. 17, 2005
Francois Kugel
|
![]()
![]()
![]()
![]()